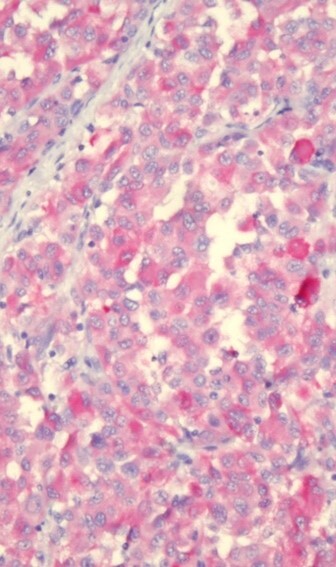

Validation, verification, or optimization? Don’t guess – here’s how to get it right!
A pathologist just asked you to bring in a new antibody or special stain – now what? Maybe you’ve got a fresh control block that needs approval, or you’re swapping products to a new vendor. Should you do a validation or verification? Or maybe an optimization? What’s the right approach? Let’s break it down in a way that makes sense.
Optimization: Finding the Sweet Spot
Optimization is a trial-and-error phase – tweaking protocols to get the best staining results. This helps fine-tune specificity and signal strength.
When do you optimize?
- Introducing a new antibody or clone
- Working with new H&E or special stains
- Adjusting preanalytical factors (processing schedules, fixation times, etc.)
- When a pathologist requests changes to a stain or antibody



Think of validation as the ultimate test drive. It confirms that a test or stain is specific, accurate, and reproducible – giving you confidence that every time you run it, you get reliable results. Before using any test on patient samples, it must be validated.
When do you validate?
- Introducing a new test
- New antibody or new clone of established antibody
- Different fixative
- New detection kit
- Decalcification
- New platform
Absolutely! CAP and CLIA set the rules and recommendations, especially for antibody validation. Here are some of the standards and guidelines to look at:
- CAP: ANP.22750 Antibody Validation/Verification
- CAP: ANP.22978 Predictive Marker Testing – Validation/Verification
- CAP: ANP.22985 Predictive Marker Testing – Decalcified Specimens
- CLIA: § 493.1253 Standard - Establishment of performance specifications




Already have a validated test but need to make a tweak? That’s where verification comes in. It ensures that any changes still meet staining quality expectations.
When do you verify?
- Switching manufacturers of an established clone
- Changing antigen retrieval methods
- Platform is moved
- Minor protocol changes (antibody dilution, incubation times)
- Checking antibody lot to lot
- Test control blocks
- Using FDA-approved kits
Yes! Just like with validation, CAP and CLIA set the rules and recommendations for verification. Here are some of the standards and guidelines to look at:
- CAP: ANP.22750 Antibody Validation/Verification
- CAP: ANP.22978 Predictive Marker Testing – Validation/Verification
- CAP: ANP.22780 ISH Assay Performance
- CLIA: § 493.1253 Standard - Establishment of performance specifications

- Validation → New test, major changes, or new platforms
- Verification → Adjustments to an already validated test
- Optimization → Fine-tuning for the best possible results
Be sure to document everything to show evidence of compliance:
- SOP: acts as your roadmap for validation, verification, or optimization process
- Number of positive and negative tissues required
- Any exemptions
- Route to approval
- Protocols used
- Records
- How or where tissue was sourced
- Lot numbers, clones, expiration dates, manufacturer, or any other information
- Run reports
- Record or form of approval that is signed
- Slides/Results
- Maintain for a minimum of two years (check your SOPs)
Recent Posts
-
CytoPath Disc - IFU Video
Watch this short video to learn how to use the new CytoPath Discs!
-
CytoPath Disc: The new way to prepare cell blocks
The CytoPath Disc is an innovative cell block preparation solution that simplifies specimen processi
-
Why Mentorship Matters in Histology
In histology, real expertise isn’t learned from textbooks, it’s built at the bench. It’s developed i





